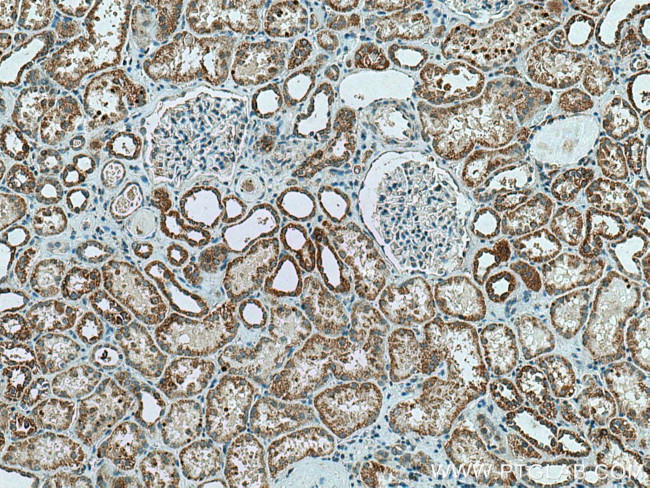
CA5B Antibody in Immunohistochemistry (Paraffin) (IHC (P))

Search
Proteintech
CA5B Polyclonal Antibody
{{$productOrderCtrl.translations['antibody.pdp.commerceCard.promotion.promotions']}}
{{$productOrderCtrl.translations['antibody.pdp.commerceCard.promotion.viewpromo']}}
{{$productOrderCtrl.translations['antibody.pdp.commerceCard.promotion.promocode']}}: {{promo.promoCode}} {{promo.promoTitle}} {{promo.promoDescription}}. {{$productOrderCtrl.translations['antibody.pdp.commerceCard.promotion.learnmore']}}
产品信息
13342-1-AP
种属反应
宿主/亚型
分类
类型
抗原
偶联物
形式
浓度
规格
纯化类型
保存液
内含物
保存条件
运输条件
产品详细信息
Immunogen sequence: MVVMNSLRV ILQASPGKLL WRKFQIPRFM PARPCSLYTC TYKTRNRALH PLWESVDLVP GGDRQSPINI RWRDSVYDPG LKPLTISYDP ATCLHVWNNG YSFLVEFEDS TDKSVIKGGP LEHNYRLKQF HFHWGAIDAW GSEHTVDSKC FPAELHLVHW NAVRFENFED AALEENGLAV IGVFLKLGKH HKELQKLVDT LPSIKHKDAL VEFGSFDPSC LMPTCPDYWT YSGSLTTPPL SESVTWIIKK QPVEVDHDQL EQFRTLLFTS EGEKEKRMVD NFRPLQPLMN RTVRSSFRHD YVLNVQAKPK PATSQATP (1-317 aa encoded by BC028142)
靶标信息
Carbonic anhydrases (CAs) are members of a large family of zinc metalloenzymes responsible for catalyzing the reversible hydration of carbon dioxide.CAs show extensive diversity in their distribution and subcellular localization.They are involved in a variety of biological processes, including calcification, bone resorption, respiration, acid-base balance and the formation of aqueous humor, saliva, gastric juice and cerebrospinal fluid. CA VB, also known as carbonate dehydratase VB, is one of two isoforms of CA V. It localizes to the mitochondria and is involved in metabolic processes. CA VB is predominantly expressed in heart, pancreas, lung, placenta, kidney and skeletal muscle. It exhibits highest homology with family member CA VA (the second isoform of CA V); however, unlike CA VA, it is not expressed in the liver, suggesting that it plays a significantly different physiological role.
仅用于科研。不用于诊断过程。未经明确授权不得转售。
生物信息学
蛋白别名: CA-VB; Carbonate dehydratase VB; Carbonic anhydrase 5B, mitochondrial; Carbonic anhydrase VB; carbonic anhydrase VB, mitochondrial; carbonic dehydratase; unnamed protein product
基因别名: 7330410H16Rik; CA-VB; CA5B; Car5b; CarVb; CAVB; D730005F19Rik
UniProt ID: (Human) Q9Y2D0, (Rat) Q66HG6, (Mouse) Q9QZA0
Entrez Gene ID: (Human) 11238, (Rat) 302669, (Mouse) 56078